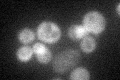
YDR280W
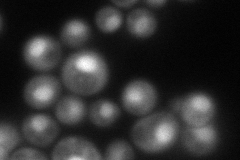
YDR280W
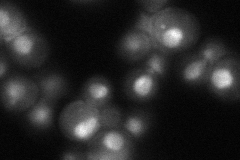
YDR280W

View description
Exosome non-catalytic core component; involved in 3'-5' RNA processing and degradation in both the nucleus and the cytoplasm; has similarity to E. coli RNase PH and to human hRrp45p (PM/SCL-75, EXOSC9)
Localization:
Intensity:
Fold change:
Significance:
-
C’ GFP library in SD
cytosol32.37 -
N' NOP1pr-GFP in SD

nucleus87.8805 -
N' TEF2pr-mCherry in SD
nucleus94.6774 -
N' NATIVEpr-GFP in SD
nucleus45.4794 -
N' TEF2pr-VC and Cyto-VN in SD

#N/A0 -
C’ GFP library in SD+DTT

cytosol20.30.62No -
C’ GFP library in SD+H2O2

cytosol34.211.05No -
C’ GFP library in Starvation Media

cytosol33.711.04No -
C’ GFP library on the background of Pup2-DaMP

cytosol -
C’ GFP library on the background of CCT mutant

cytosol34.92851.07852No
